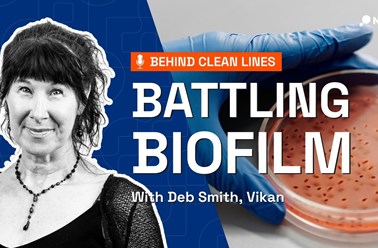

Arkiverede nyheder!
Velkommen til vores sektion med arkiverede nyheder!
Selv om disse historier måske ikke er de nyeste, er de stadig en værdifuld kilde til indsigt, innovation og udvikling i branchen.
Udforsk tidligere artikler, produktlanceringer og diskussioner, der har formet fødevareforarbejdningssektoren. Viden bliver aldrig forældet - dyk ned og genopdag vigtige øjeblikke!